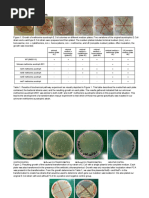

100% found this document useful (1 vote)
457 views41 pagesOrganic Chemistry Chapter 1: Structure & Bonding
This document contains a chapter on organic chemistry structure and bonding from an organic chemistry textbook. It includes 53 multiple choice and free response questions on topics like electron configurations, Lewis structures, formal charges, resonance structures, and bond polarity. The questions range from basic to advanced and cover key concepts that are essential to understanding organic chemistry.
Uploaded by
Yelo AlmasenCopyright
© © All Rights Reserved
We take content rights seriously. If you suspect this is your content, claim it here.
Available Formats
Download as DOCX, PDF, TXT or read online on Scribd
100% found this document useful (1 vote)
457 views41 pagesOrganic Chemistry Chapter 1: Structure & Bonding
This document contains a chapter on organic chemistry structure and bonding from an organic chemistry textbook. It includes 53 multiple choice and free response questions on topics like electron configurations, Lewis structures, formal charges, resonance structures, and bond polarity. The questions range from basic to advanced and cover key concepts that are essential to understanding organic chemistry.
Uploaded by
Yelo AlmasenCopyright
© © All Rights Reserved
We take content rights seriously. If you suspect this is your content, claim it here.
Available Formats
Download as DOCX, PDF, TXT or read online on Scribd